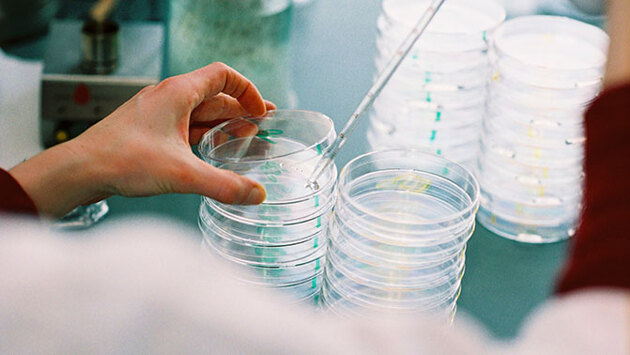
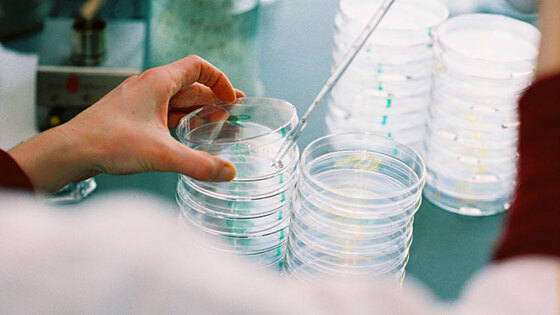

Ученые составили список продуктов, снижающих риск развития рака
Это открытие может способствовать созданию нового лекарственного препарата.
Диета с высоким содержанием пищевых волокон снижает шансы заболеть колоректальным раком. К такому выводу пришли ученые из Великобритании. Как пишут РИА Новости, эксперимент провели специалисты из британского Института Бабрахама.
Как отмечается, в ходе исследования специалисты выявили связь между потреблением пищевых волокон и производством короткоцепочечных жирных кислот, уменьшающих количество белка HDAC2. Именно его появление связывают с вероятностью возникновения онкологического заболевания. Медики выявили, что КЖК производятся организмом, когда происходит ферментация пищевых волокон, которыми богаты овощи, фрукты и крупы.
Это открытие может способствовать созданию нового лекарственного препарата, резюмируют специалисты.
Напомним, ранее СМИ сообщили, что женщины, которые работают в ночную смену, намного чаще страдают от некоторых видов рака по сравнению с другими представительницами слабого пола.